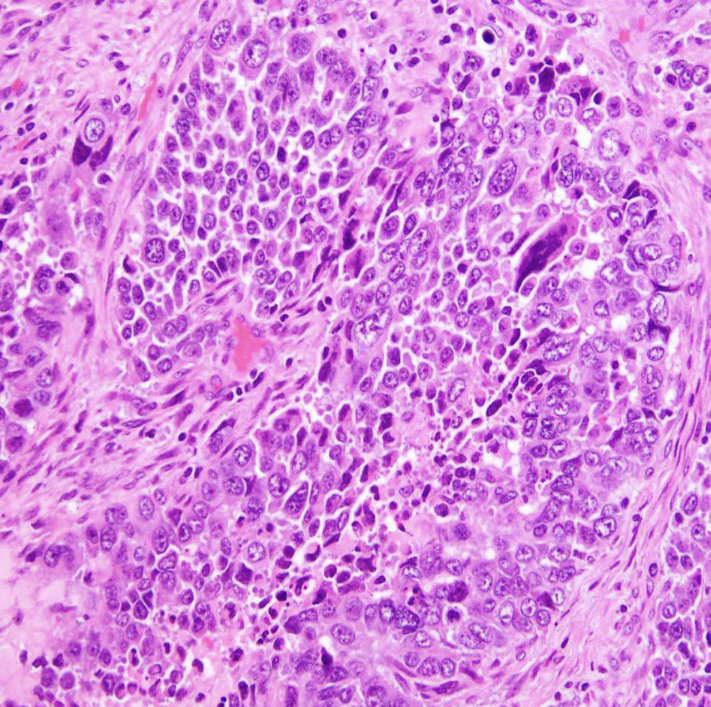

Victor R. Ambros (최종현학술원 주최 강연, 2025.02.07)
2025.03.09

C.elegans에 대한 연구와 miRNA의 발견 2024년 노벨생리의학상 수상자 Victor R. Ambros
출처
https://blog.naver.com/verslanature/223751551401
이슈모어 핫이슈
-
 배우 전소영 조용히 치고 올라왔다 넷플릭스 이어 티빙까지 잡은 이유
배우 전소영의 최근 행보가 단순한 신인 배우의 활동 흐름을 넘어서는 움직임으로 평가되고 있다. 넷플릭스 작품…
배우 전소영 조용히 치고 올라왔다 넷플릭스 이어 티빙까지 잡은 이유
배우 전소영의 최근 행보가 단순한 신인 배우의 활동 흐름을 넘어서는 움직임으로 평가되고 있다. 넷플릭스 작품…
-
 윤재찬, 살목지 한 편으로 존재감 폭발…무명 이미지 지워낸 순간
영화 살목지 윤재찬이 단 한 편의 작품으로 자신의 존재감을 완전히 끌어올렸다. 단순한 신인 배우의 데뷔를 넘…
윤재찬, 살목지 한 편으로 존재감 폭발…무명 이미지 지워낸 순간
영화 살목지 윤재찬이 단 한 편의 작품으로 자신의 존재감을 완전히 끌어올렸다. 단순한 신인 배우의 데뷔를 넘…
-
 샤를리즈 테론 넷플릭스 정점 공개 동시에 터졌다 액션 판도 뒤집은 한 장면
샤를리즈 테론 넷플릭스 신작 ‘정점(Apex)’이 공개되면서 글로벌 시청자 반응이 빠르게 확산되고 있다. 단…
샤를리즈 테론 넷플릭스 정점 공개 동시에 터졌다 액션 판도 뒤집은 한 장면
샤를리즈 테론 넷플릭스 신작 ‘정점(Apex)’이 공개되면서 글로벌 시청자 반응이 빠르게 확산되고 있다. 단…
관련 포스팅
Copyright blog.dowoo.me All right reserved.